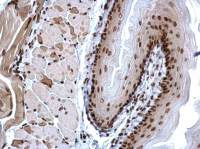
Histone H3K4me3 (Tri-methyl Lys4) antibody

GeneTex
精品推荐0
- 一级抗体
- 二级抗体
- 蛋白质和多肽
- ELISA试验盒
该分类产品即将上线哦~
商铺视频查看全部
热门推荐查看全部
关于我们查看全部

GeneTex
GeneTex GeneTex 公司于1997年成立于美国得克萨斯州的圣安东尼奥(现已迁至南加州),是由三位国际知名的科学家创立,公司致力于开发各种基础医学相关的新型研究用抗体。公司起初的核心目标在于协助科学家寻找引发人类乳腺癌的分子新靶标,现在已经逐步扩展到其他研究领域的新抗体开发和配套诊断试剂上。至今,GeneTex 抗体所含盖的领域从神经学、血液血管学、免疫学、代谢机制、细胞分子传递、干细胞研究、老化、遗传学、分子癌病学、感染病诊断与研究,乃至于斑马鱼模式动物抗体等,并提供完善的客制化抗体制备服务。 GeneTex 公司曾与多家著名抗体公司合作业务,有优秀的科学家及生物信息专家设计抗原,并利用100%

























![CDK2 (phospho Tyr15) antibody [HL1474] CDK2 (phospho Tyr15) antibody [HL1474]](https://img1.dxycdn.com/2022/0615/559/1975114919791064553-14.jpg!wh200)